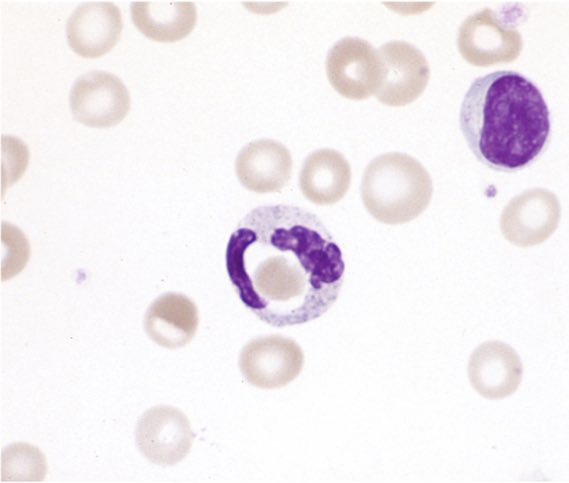
Nico Gagelmann tweet media
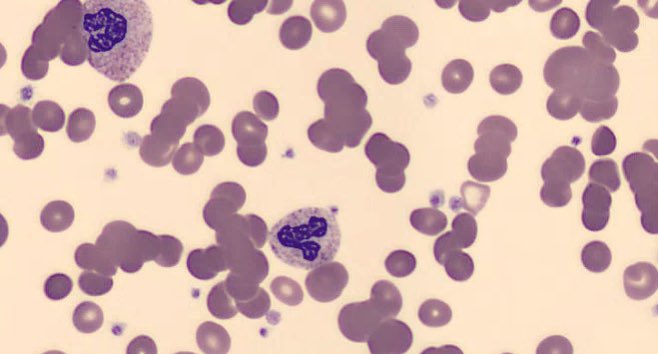
Robert Brodsky tweet media

Roman Schimmer retweetledi

To the incredible healthcare professionals who remained behind to care for patients while your colleagues attended the #ASH24 congress in San Diego, we extend our deepest gratitude. Your dedication and selflessness ensure that patient care remains a constant priority, even as the field advances through events like this #ASH24 . Thank you for your compassion, and for keeping the heart of healthcare beating strong.
@ASH_hematology @TheIACH @COMyCongress @Mohty_EBMT
English